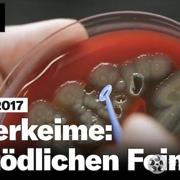

超级细菌、海洋垃圾等已经严重危及到地球的环境,人类如果不注重环保,治理环境,终将被自然吞噬,人工智能的出现、科学技术的发展都为人类提供了更多的可能性,人类应该合理利用科技,保护自然环境,让人类生活的环境变得更好。
有毒的未来 NZZ Format 2017下载帮助:
- 1、对于磁力链接和电驴链接,推荐使用115网盘、百度网盘离线下载,或使用qBittorrent下载磁力链接,迅雷下载电驴链接。
- 2、点此下载安装115网盘 ,点此下载安装qBittorrent
- 3、电脑版百度网盘离线指南,手机版百度网盘离线指南
- 4、如本站页面打开困难,可访问镜像站 docu-hub.com